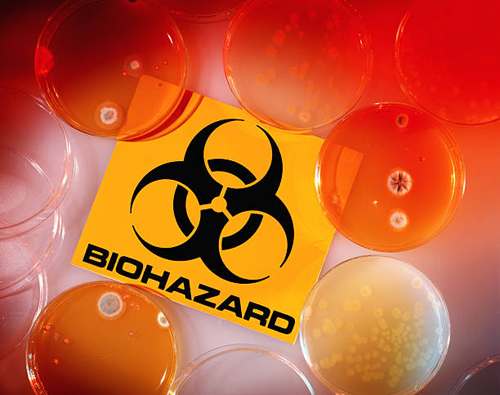

Un scientifique canadien au centre d’une enquête chinoise de bio-espionnage retrouvé mort en Afrique ?
Mise à jour : Il semble que M. Plummer ait pris l’habitude de se faire « voler » le matériel biologique sur lequel il travaillait, car nous avons trouvé un rapport de 2009 dans le Winnepeg Free Press qui détaille que le vol de 22 flacons de matériel biologique a été « confirmé par le directeur scientifique, le Dr Frank Plummer ».

Plummer aurait alerté les autorités sur le matériel manquant le jour même où un ancien chercheur de vaccins a été arrêté par des agents spéciaux du FBI après que les douanes américaines aient découvert les flacons remplis d’un gant dans le coffre de sa voiture au poste frontière du Manitoba et du Dakota du Nord.
Certaines des fioles contenaient des gènes du virus mortel Ebola, mais les scientifiques locaux affirment que le matériel n’est pas infectieux.
Mais plus d’une semaine après que le vol a été révélé, la police a déclaré que personne du laboratoire n’avait signalé l’incident.
Plummer a déclaré que le chercheur avait signé un formulaire déclarant qu’il n’avait rien volé au laboratoire et qu’il avait compris qu’il n’en avait pas le droit. Le laboratoire national ne procède pas à des fouilles du personnel lorsqu’il sort du laboratoire et ne fait pas l’inventaire systématique des milliers de flacons contenant des substances biologiques non infectieuses.
Cependant, des documents judiciaires allèguent que l’ancien chercheur a volé les flacons lors de son dernier jour de travail au laboratoire de virologie en janvier parce qu’il « ne voulait pas recommencer ses recherches depuis le début lorsqu’il est entré dans sa prochaine recherche » avec les National Institutes of Health au Biodefense Research Laboratory dans le Maryland.
Tout cela est très intrigant.
* * *
Tel que GreatGameIndia.com l’a détaillé plus tôt, dans une tournure très étrange des événements, le scientifique renommé Frank Plummer qui a reçu un échantillon de coronavirus du SRAS saoudien et qui travaillait sur un vaccin contre le coronavirus (VIH) dans le laboratoire canadien basé à Winnipeg d’où le virus a été introduit clandestinement par des agents de guerre biologique chinois et utilisé comme arme, comme l’a révélé l’enquête de GreatGameIndia, est mort dans des conditions mystérieuses.
Frank Plummer était la clé de l’affaire de l’espionnage biologique chinois au Laboratoire national de microbiologie de Winnipeg. [Certains des articles suivants sont en anglais malheureusement]
– Exclusif : Coronavirus Bioweapon – Comment les agents chinois ont volé le Coronavirus au Canada et l’ont transformé en arme.
– Article à lire absolument, publié dans le monde entier : Coronavirus – Le plan secret de la Chine pour l’armement des virus.
– Mise à jour : Des agents de guerre biologique chinois de l’Université d’ Harvard pris en flagrant délit de contrebande de virus mortels.
Selon CBC, M. Plummer, 67 ans, était au Kenya, où il était l’un des principaux orateurs de la réunion annuelle du centre de collaboration de l’université de Nairobi pour la recherche et la formation sur le VIH/sida et les maladies sexuellement transmissibles (MST).
Le Dr Larry Gelmon, qui a participé à l’organisation de cette réunion, a déclaré que Plummer s’était effondré et avait été transporté à l’hôpital de Nairobi, où son décès a été constaté à son arrivée.
Plummer est né et a grandi à Winnipeg, où il a dirigé le Laboratoire national de microbiologie du Canada pendant plusieurs années.
Il a également participé à un partenariat de recherche novateur entre l’Université du Manitoba et l’Université de Nairobi, établi avant que le monde ne soit très conscient du VIH/sida.
« Il a aidé à identifier un grand nombre de facteurs clés qui sont impliqués dans la transmission du VIH à ses débuts », a déclaré Keith Fowke, professeur au département de microbiologie médicale et de maladies infectieuses de l’Université du Manitoba.
« Il était tellement empli d’espoir qu’il était sûr que son périple allait se terminer par la découverte d’un vaccin contre le VIH – le chemin qu’il avait enatmé il y a presque 30 ans », a déclaré le collègue de Plummer, le Dr Allan Ronald.
Ce qui n’est pas mentionné dans le reportage de la CBC, cependant, c’est que M. Plummer travaillait dans le même laboratoire national de microbiologie (LNM) à Winnipeg, au Canada, d’où l’agent de guerre biologique chinoise Xiangguo Qiu et ses collègues ont fait passer clandestinement le coronavirus du SRAS à l’Institut de virologie de Wuhan, en Chine, où il aurait été utilisé comme arme et aurait fait l’objet d’une fuite.
En fait, comme GreatGameIndia l’a rapporté dans son rapport exclusif sur les armes biologiques à base de coronavirus, c’est le directeur scientifique Frank Plummer qui a acquis l’échantillon de coronavirus du SRAS du patient saoudien au laboratoire NML de Winnipeg auprès de Ron Fouchier, un virologiste de premier plan du Centre médical Erasmus (EMC) de Rotterdam, aux Pays-Bas, qui a reçu le virus du virologiste égyptien Dr Ali Mohamed Zaki qui a isolé et identifié un type de coronavirus jusqu’alors inconnu dans les poumons du patient saoudien.
Fouchier a séquencé le virus à partir d’un échantillon envoyé par Zaki en utilisant une méthode d’amplification en chaîne par polymérase en temps réel (RT-PCR) à large spectre « pan-coronavirus » pour tester les caractéristiques distinctives d’un certain nombre de coronavirus connus pour infecter l’homme.
Cet échantillon de coronavirus est arrivé au laboratoire (NML) canadien à Winnipeg le 4 mai 2013, en provenance du laboratoire néerlandais et a été reçu par Frank Plummer. Le laboratoire canadien a constitué des stocks de ce virus et l’a utilisé pour évaluer les tests de diagnostic utilisés au Canada. Les scientifiques de Winnipeg ont travaillé pour voir quelles espèces animales peuvent être infectées par le nouveau virus.
Les recherches ont été menées en collaboration avec le laboratoire national de l’Agence canadienne d’inspection des aliments, le Centre national des maladies animales exotiques, qui est installé dans le même complexe que le Laboratoire national de microbiologie.
Ce laboratoire canadien basé à Winnipeg a été la cible d’agents chinois dans ce que l’on pourrait qualifier de bio-espionnage. Les virus auraient été volés dans le laboratoire canadien par l’agent de guerre biologique chinoise Xiangguo Qiu et ses collègues, puis introduits clandestinement dans nul autre que l’Institut de virologie de Wuhan, où le virus aurait été utilisé comme arme et aurait fui.
En outre, Frank Plummer travaillait également sur un vaccin contre le VIH et une étude intéressante publiée récemment a révélé que des scientifiques indiens avaient trouvé des injections de type VIH dans le coronavirus de Wuhan – la clé qui a permis de faire le saut vers les gens. Les scientifiques indiens ont été massivement critiqués en ligne par les experts des médias sociaux et ont été contraints de retirer leur étude, en représailles de laquelle les autorités indiennes ont maintenant ouvert une enquête contre l’Institut de virologie de Wuhan en Chine. Il convient toutefois de noter que la Chine a maintenant commencé à utiliser un vaccin contre le VIH pour soigner les cas atteints de coronavirus.

Frank Plummer a été la clé de toute l’enquête sur les origines de l’arme biologique Coronavirus. Mais le gouvernement canadien va-t-il ouvrir une enquête sur cette question ? Contrairement à leurs homologues américains qui ont accusé les agents de guerre biologique chinois d’avoir tenté de faire passer des virus mortels depuis l’université d’Harvard, les détails de l’enquête canadienne sur l’affaire de l’espionnage biologique de Winnipeg sont entourés de secret.
yogaesoteric
8 avril 2020
